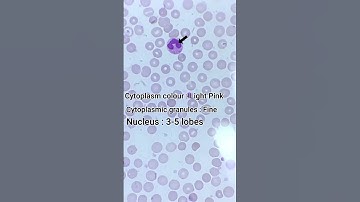
Identify WBC Under Microscope | A Systematic Approach |  #shorts

⬇ DOWNLOAD NOW
Kalau muncul iklan pop-up, tutup lalu klik tombol kembali
Download lagu look 👀 like at WBC under the microscope 😳#shorts #science secara gratis hanya untuk keperluan promosi. Dukung artis favorit kamu dengan membeli musik original di iTunes atau platform resmi lainnya.
 White blood cells fight infection under the microscope! RARE FOOTAGE!
White blood cells fight infection under the microscope! RARE FOOTAGE!
 White Blood Cells fighting under microscope!
White Blood Cells fighting under microscope!
 Parasite VS White Blood Cell 🔬 #microscope #science #microscopic
Parasite VS White Blood Cell 🔬 #microscope #science #microscopic
 Rare Pics of WBC cells||amazing microscopic world 🌎 #bloodtest #microscope #shortsvideo
Rare Pics of WBC cells||amazing microscopic world 🌎 #bloodtest #microscope #shortsvideo
Identify WBC Under Microscope | A Systematic Approach | #shorts
Identify WBC Under Microscope | A Systematic Approach | #shorts
 Check out blood under the microscope #blood
Check out blood under the microscope #blood
 Blister Fluid Under Microscope (White Blood Cells)
Blister Fluid Under Microscope (White Blood Cells)
 White Blood cells#shortsvideo #microscope
White Blood cells#shortsvideo #microscope